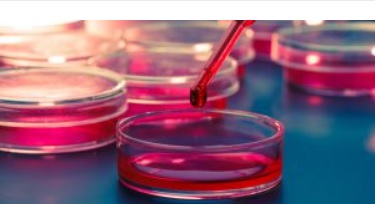
Сторожинецька лікарня переплатить новоствореному підприємцю понад 100 тисяч за аналізатор крові

Сторожинецька лікарня переплатить новоствореному підприємцю понад 100 тисяч за аналізатор крові
Сторожинецька центральна районна лікарня (Чернівецька область) 30 жовтня підписала договір із приватним підприємцем Владиславом Шнайдером на закупівлю аналізатора крові за 311 тис. грн. Про це стало відомо з порталу публічних закупівель Prozorro.
Закупівлю провели за спрощеною процедурою звітування, оскільки придбання такого товару передбачене постановою Кабінету Міністрів, і використовується для запобігання поширенню, локалізації та ліквідації спалахів, пандемій коронавірусної хвороби COVID-19.
За договором, придбають аналізатор газів крові та електролітів Edan i15. Прилад використовують для проведення експрес-тестів та обробки результатів аналізів крові.
Варто зазначити, що на ринку його вартість є значно нижчою. У компанії «Лабвіта» нам підтвердили наявність таких аналізаторів за ціною 230 тис. грн, але для постачальників та дилерів, які замовляють товар у компанії, ціна на 20% нижча, тобто 184 тис. грн. Отож, Сторожинецька лікарня придбає необхідне обладнання із переплатою понад 100 тис. грн.
Аналізатори Edan i15 медзаклади України замовляють досить рідко. З початку 2019 року їх придбали лише чотири одиниці, включно із замовленням сторожинецької лікарні. Валківська районна влікарня (Харківська область) заплатила за цей прилад ще більше – 353 тис. грн. Однак у березні Кролевецька лікарня (Сумська область) замовила аналізатор всього за 200 тис. грн.
Нагадаємо, що таку ж переплату ми фіксували раніше, у липні Тячівська районна лікарня придбала Аналізатори Edan i15 також за 311 тис. грн у ТОВ «Західлабтест».
Владислав Шнайдер прописаний у Тернополі і зареєструвався приватним підприємцем наприкінці вересня 2020 року. Перше державне замовлення отримав 23 жовтня. З цього часу Владислав Шнайдер підписав 4 контракти на 358 тис. грн із врахуванням даної угоди.
Ця публікація стала можливою завдяки підтримці British Embassy Kyiv в рамках проєкту з протидії порушенням в державних закупівлях під час пандемії COVID-19 у Західній Україні. Погляди, висновки, рекомендації, висловлені в цій публікації, належать журналістам «Наші гроші. Львів» і можуть не збігатися з офіційною позицією Уряду Великої Британії.
Джерело: http://lviv.nashigroshi.org/2020/11/04/storozhynetska-likarnya-pereplatyt-novostvorenomu-pidpryyemtsyu-ponad-100-tysyach-za-analizator-krovi/




